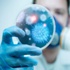
قطر تعلن عن إصابة جديدة بفيروس كورونا

أخرى من إقتصاد »

وزير الدفاع الإسرائيلي: نحارب داعش سراً لعدم إحراج العرب
23 أكتوبر 2014 15:04 لا توجد صورايكويت تفوز بجائزتين اقليميتين
23 أكتوبر 2014 15:02 لا توجد صور"المصفاة" تمتنع عن تزويد أصحاب "مستودعات الغاز " بالاسطوانات (...
23 أكتوبر 2014 15:01
عساف: لولا مصر ما كنا نجحنا في وقف العدوان الإسرائيلي على غزة
23 أكتوبر 2014 14:17 لا توجد صورانتعاش النشاط الاقتصادي في منطقة اليورو خلال الشهر الجاري
23 أكتوبر 2014 14:10 لا توجد صورالسويدي: بداية الإصلاح والتنمية تبدأ من الشارع ولا بد من إعادة...
23 أكتوبر 2014 14:10 لا توجد صورالاسترليني يتراجع بعد بيانات التجزئة البريطانية
23 أكتوبر 2014 14:10 لا توجد صوراتجاه كبير لدى الشركات الاميركية لاعادة انتاجها الى الولايات ا...
23 أكتوبر 2014 14:10 لا توجد صورمستويات قياسية لاعداد الزوار الاجانب الى اسبانيا الصيف الماضي
23 أكتوبر 2014 14:10
الرئيس التنفيذي: آبل تنوي فتح 25 متجرا في الصين خلال عامين
23 أكتوبر 2014 14:10 لا توجد صور«إمارات» تخفّض سعر الديزل 20 فلساً
23 أكتوبر 2014 14:10 لا توجد صورحامد: ميناء الغاز المسال سيكون جاهزاً مع بداية أيار المقبل
23 أكتوبر 2014 14:10 لا توجد صورنيكي يغلق منخفضا بعد فشل بيانات صينية في تهدئة مخاوف النمو
23 أكتوبر 2014 14:10 لا توجد صورعرض مشاريع عقارية بـ 15 مليار ريال في السعودية
23 أكتوبر 2014 14:10 لا توجد صور2.7 مليار دينار إجمالي الإيرادات الضريبية لنهاية آب الماضي
23 أكتوبر 2014 14:10 لا توجد صورتراجع جماعي لمؤشرات البورصة في الدقائق الأولى للتعامل اليوم
23 أكتوبر 2014 14:10 لا توجد صوردانة غاز" الإماراتية " تتسلم 47 مليون دولار من مستحقاتها في مصر
23 أكتوبر 2014 14:10 لا توجد صورالمجتمعات العمرانية تطرح 4 مناقصات عامة
23 أكتوبر 2014 14:07 لا توجد صورمعيط يشارك فى اجتماعات اتحاد مراقبى التأمين
23 أكتوبر 2014 14:07 لا توجد صورفيديو وصور- البدوى ضيف شرف مؤتمر الحزب الحاكم بالسودان
23 أكتوبر 2014 14:07
«سابك» تلغي اتفاقية توسعة مشروع شراكتها مع «شل»
23 أكتوبر 2014 14:03 لا توجد صوراختتام دورة تدريبية في مركز التدريب الإحصائي الأردني
23 أكتوبر 2014 14:02
الحكومة تدرس بيع حصة المصرية للاتصالات في فودافون لجهة سيادية
23 أكتوبر 2014 13:15 لا توجد صورننشر حركة الملاحة بالبحر الأحمر
23 أكتوبر 2014 12:15 لا توجد صورأحمد نور يتعهد بالقضاء على الجرائم الثقافية
23 أكتوبر 2014 13:13 لا توجد صورالاتحاد الأوروبى يهدد إسرائيل بسبب المستوطنات
23 أكتوبر 2014 13:13
خدمة الاحتياط بالجيش كابوس يلاحق شباب دمشق
23 أكتوبر 2014 13:05 لا توجد صورألمانيا: الصين تحولت من آخذ لمانح
23 أكتوبر 2014 13:04
ألمانيا تحتفظ بصدارة تصنيف الفيفا .. والأخضر يتراجع 15 مركز
23 أكتوبر 2014 13:04
خامنئي يدعو لخفض اعتماد بلاده على إيرادات النفط
23 أكتوبر 2014 13:02 لا توجد صورتكثيف أمنى مشدد بجامعة الأزهـر
23 أكتوبر 2014 11:12 لا توجد صورننشر شروط الحجز بشقق الإسكان المتوسط
23 أكتوبر 2014 12:15 لا توجد صورميناء الإسكندرية يستقبل 801 سائح من جنسيات مختلفة
23 أكتوبر 2014 12:15
مسؤولون إسرائيليون يتهمون السلطة وعباس بالتحريض على العنف في ا...
23 أكتوبر 2014 12:13
مجلس الشورى السعودي يطالب بسداد 39 مليار ريال للصندوق العقاري ...
23 أكتوبر 2014 12:12 لا توجد صورالكويت توقف تصاريح موظفي شركة سعودية ردًا على إغلاق "الخفجي"
23 أكتوبر 2014 12:08 لا توجد صور"الشورى" يمنع الإعلام من حضور مناقشة تقرير "نزاهة"
23 أكتوبر 2014 12:08
بريطانيا تستعد لطرد تنظيمات الإخوان المسلمين من أراضيها
23 أكتوبر 2014 12:07
تراجع كبير في أرباح هيونداي موتور خلال الربع الثالث
23 أكتوبر 2014 11:12 لا توجد صورمقتل 5 أشخاص واصابة 12 في انفجار وقع في محطة للحافلات شمال نيج...
23 أكتوبر 2014 12:03 لا توجد صورافتتاح أعمال منتدى فرص الاستثمار الصناعي بالقصيم في السعودية
23 أكتوبر 2014 12:01 لا توجد صور"الخطوط القطرية" تستعد لتسيير رحلات على متن "ايرباص A380" إلى ...
23 أكتوبر 2014 12:01 لا توجد صورشركة البحرين للملاحة تعلن خسارة عقد بيع بإجمالي أرباح 1.2 مليو...
23 أكتوبر 2014 12:01
ارتفاع صادرات وواردات المملكة غير البترولية بـ 22%
23 أكتوبر 2014 11:12
قطر تعلن عن إصابة جديدة بفيروس كورونا
23 أكتوبر 2014 11:08
"الشركة العامة العقارية" تلغي إدراج أسهمها في البورصة المغربية...
23 أكتوبر 2014 11:07
اضراب عام يشل مؤسسات غزة الحكومية للمطالبة بدفع رواتب الموظفين...
23 أكتوبر 2014 11:07
العاملون في فندق باريسي فخم تملكه قطر يضربون للمطالبة بزيادة ا...
23 أكتوبر 2014 11:07
احتدام الخلاف بين الحزب الاشتراكي الفرنسي الحاكم وبين انصار ال...
23 أكتوبر 2014 11:07
الشرطة الايطالية توجه تهمة التهرب الضريبي لكانافارو - أ. ف. ب.
23 أكتوبر 2014 11:07
مقتل إسرائيلية وإصابة 8 فى حادث دهس في القدس المحتلة
23 أكتوبر 2014 11:03
التربية تحدد قواعد لإعارة ونقل خدمات شاغلي الوظائف التعليمية
23 أكتوبر 2014 11:02
مختصون يطالبون باستثناء إسرائيل من مشروع "البحرين"
23 أكتوبر 2014 10:11
العراق.. 20 خبيراً عسكرياً أميركياً يصلون عين الأسد
23 أكتوبر 2014 10:08
انتخاب الصيني تشاو هولين رئيسا للاتحاد الدولي للاتصالات
23 أكتوبر 2014 10:06 لا توجد صورصافي ربح كريدي سويس يفوق التوقعات في الربع/3
23 أكتوبر 2014 10:04 لا توجد صورمؤشر الأسهم يعزز بقاءه فوق مستوى 10 آلاف للجلسة الثانية
23 أكتوبر 2014 10:04
السفيرة كيلة تحث البرلمانيين الإيطاليين الاعتراف بدولة فلسطين
23 أكتوبر 2014 08:13 لا توجد صوربوينغ تحول زيت الطهي المستعمل إلى وقود طائرات
23 أكتوبر 2014 07:12
اسرائيل تتجاوز صلاحيات الاوقاف وتسيطر على ابواب الاقصى
23 أكتوبر 2014 07:10أخبار ساخنة من إقتصاد »
جديد من إقتصاد »
- جمعية مصنعي القاهرة الجديدة تبحث فرص التعا...
- خدمة العملاء بالمقدمة.. ما الوظائف الأكثر ...
- رئيس غرفة صناعة الحبوب: 40% زيادة في سعر ا...
- "حماية المنافسة" يكشف اتفاق 21 عيادة جلدية...
- الغرفة التجارية: 30% انخفاضًا في أسعار الخ...
- تيسلا Supercahrge تتخطى 30,000 نقطة عالمياً
- اقتصاد منطقة اليورو ينمو بـ 2.2% في الربع ...
- للمرة الثانية.. البرلمان يطيح بمرشح الرئيس...
- مجلس الوزراء: السماح للجهات الحكومية بـ«ال...
- حفتر يترشح للرئاسة: ليس طلبا للسلطة
- تقنية الأحساء والزراعة تدشنان 100 شتلة ضمن...
- أمانة عسير تُعالج 31 ألف بلاغ عن التشوهات ...
- «الصحة»: 37 إصابة جديدة بـ«كورونا» ووفاتان...
- حزب تونسي يدعو إلى تفكيك «الأخطبوط الإخواني»
- كسر جمجمة شرطي بولندي في مواجهات مع مهاجرين
- القصاص من مقيم قتل مواطناً بإطلاق النار عل...
- «الأرصاد»: انخفاض الحرارة إلى 6 درجات في 4...
- صفقات وتعهدات باستثمارات ضخمة في القارة ال...
- الإمارات تستضيف معرض ومؤتمر «سايبر تك جلوب...
- الإمارات تعلن عن استثمارات جديدة بقيمة 6 م...


